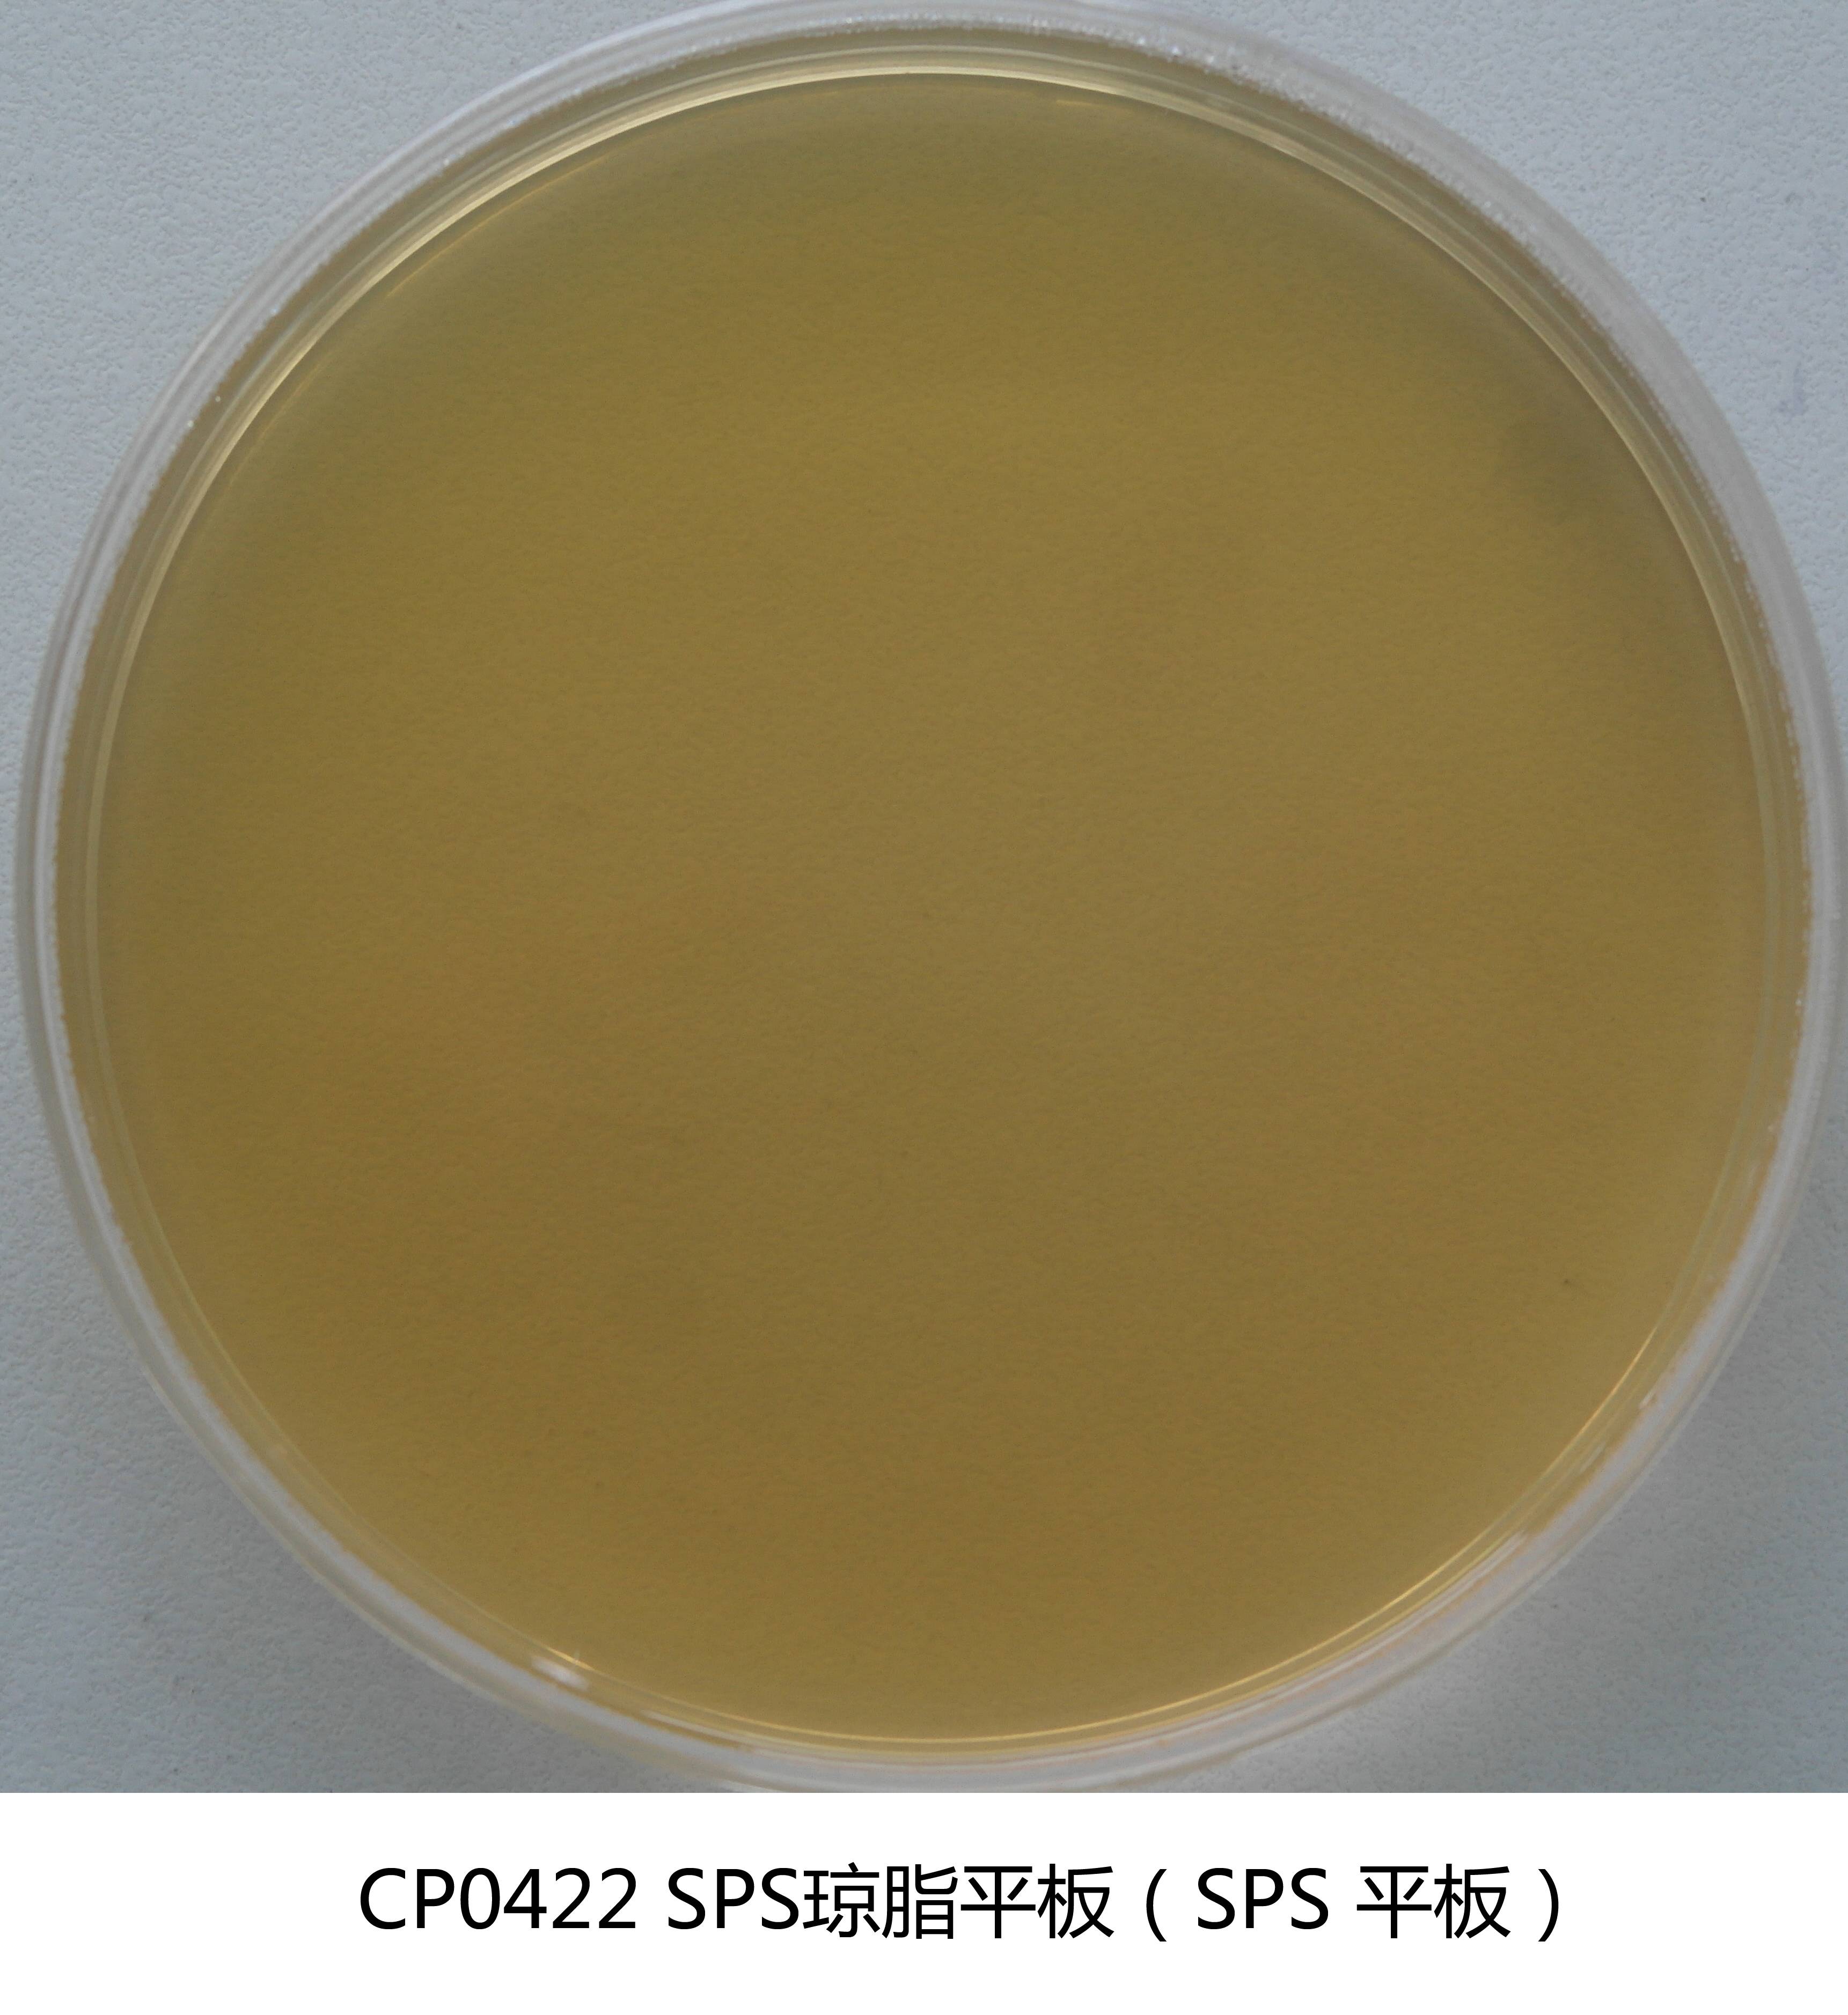
SPS琼脂平板培养基(亚硫酸盐-多粘菌素-磺胺嘧啶琼脂) 90mm×20个

商品详细
说明书
微生物图册
行业应用
相关论文
产品名称:亚硫酸盐-多粘菌素-磺胺嘧啶琼脂配套试剂
英文名称:Additives for SPS
产品编号与包装规格:
| 产品编号 | 产品类型 | 包装规格 |
| SR0150 | 试剂A为无色液体;试剂B是为冻干试剂 | 2×5支/盒 |
产品用途:试剂A和试剂B各一支添加于100mL(028031)中配成SPS。
配方成分:
试剂A
| 配方(每升) | 含量 |
| 亚硫酸钠 | 100.0mg |
试剂B
| 配方(每升) | 含量 |
| 磺胺嘧啶钠 | 12.0mg |
| 多粘菌素B | 1.2mg |
使用方法:
1、西林瓶的打开方法: 本西林瓶在铝盖上有箭头的标志,开启西林瓶前,用75%酒精棉消毒西林瓶表面,在无菌条件下,按铝盖上的箭头方向打开铝盖,撕开铝盖,打开西林瓶胶塞。
2、试剂的使用方法:在试剂B中加入1mL无菌生理盐水,使试剂完全溶解,添加于100mL(028031)中,再添加试剂A一支,配成SPS。
储存条件与保质期:2-8℃保存,有效期两年。
废物处理:检测之后带菌物品置于121℃下高压灭菌30分钟后处理。
执行标准:Q/HK 0709 微生物检测配套试剂